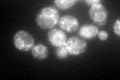
YBL040C
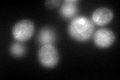
YBL040C
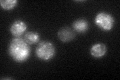
YBL040C

View description
HDEL receptor, an integral membrane protein that binds to the HDEL motif in proteins destined for retention in the endoplasmic reticulum; has a role in maintenance of normal levels of ER-resident proteins
Localization:
Intensity:
Fold change:
Significance:
-
C’ GFP library in SD
punctate:ER101.11 -
N' NOP1pr-GFP in SD

N/A0 -
N' TEF2pr-mCherry in SD

N/A0 -
N' NATIVEpr-GFP in SD

N/A0 -
N' TEF2pr-VC and Cyto-VN in SD

N/A0 -
C’ GFP library in SD+DTT
punctate.ER120.121.18No -
C’ GFP library in SD+H2O2

punctate.ER101.111No -
C’ GFP library in Starvation Media
punctate,ER108.51.07No -
C’ GFP library on the background of Pup2-DaMP

punctate:ER -
C’ GFP library on the background of CCT mutant

punctate:ER89.07290.880888No
